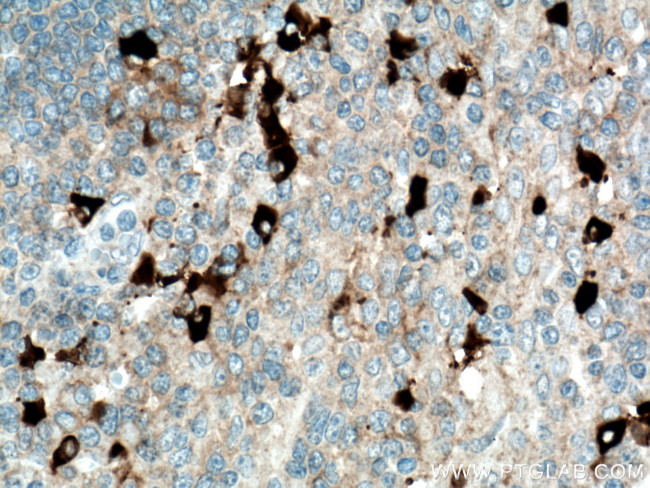
Human IgG4 Antibody in Immunohistochemistry (Paraffin) (IHC (P))

Search
Proteintech
Human IgG4 Monoclonal Antibody (1A1A2), Biotin
{{$productOrderCtrl.translations['antibody.pdp.commerceCard.promotion.promotions']}}
{{$productOrderCtrl.translations['antibody.pdp.commerceCard.promotion.viewpromo']}}
{{$productOrderCtrl.translations['antibody.pdp.commerceCard.promotion.promocode']}}: {{promo.promoCode}} {{promo.promoTitle}} {{promo.promoDescription}}. {{$productOrderCtrl.translations['antibody.pdp.commerceCard.promotion.learnmore']}}
产品信息
BIOTIN-66408
种属反应
宿主/亚型
分类
类型
克隆号
抗原
偶联物
形式
浓度
规格
纯化类型
保存液
内含物
保存条件
运输条件
产品详细信息
This antibody detects the heavy chain of human IgG4. The immunogen of this antibody is the specific domain "NKGLPSSIEK" of IGHG4. This antibody is Biotin conjugated.
靶标信息
Human IgG4, also known as human immunoglobulin G4, is a subclass of human IgG antibodies that is produced by the immune system in response to antigens. It is the least abundant subclass of IgG in the blood and plays a minor role in defense against pathogens. IgG4 works by binding to specific antigens and promoting their clearance from the body through various mechanisms, including phagocytosis and complement activation. IgG4 is also involved in other immune responses, such as immune tolerance and suppression of inflammation. Human IgG4 can be used in research to study the immune response to pathogens and to develop diagnostic tests and therapeutic interventions for infectious and autoimmune diseases.
仅用于科研。不用于诊断过程。未经明确授权不得转售。
篇参考文献 (0)
生物信息学
蛋白别名: Immunoglobulin G; Immunoglobulin G4; ImmunoglobulinG
Entrez Gene ID: (Human) 3503